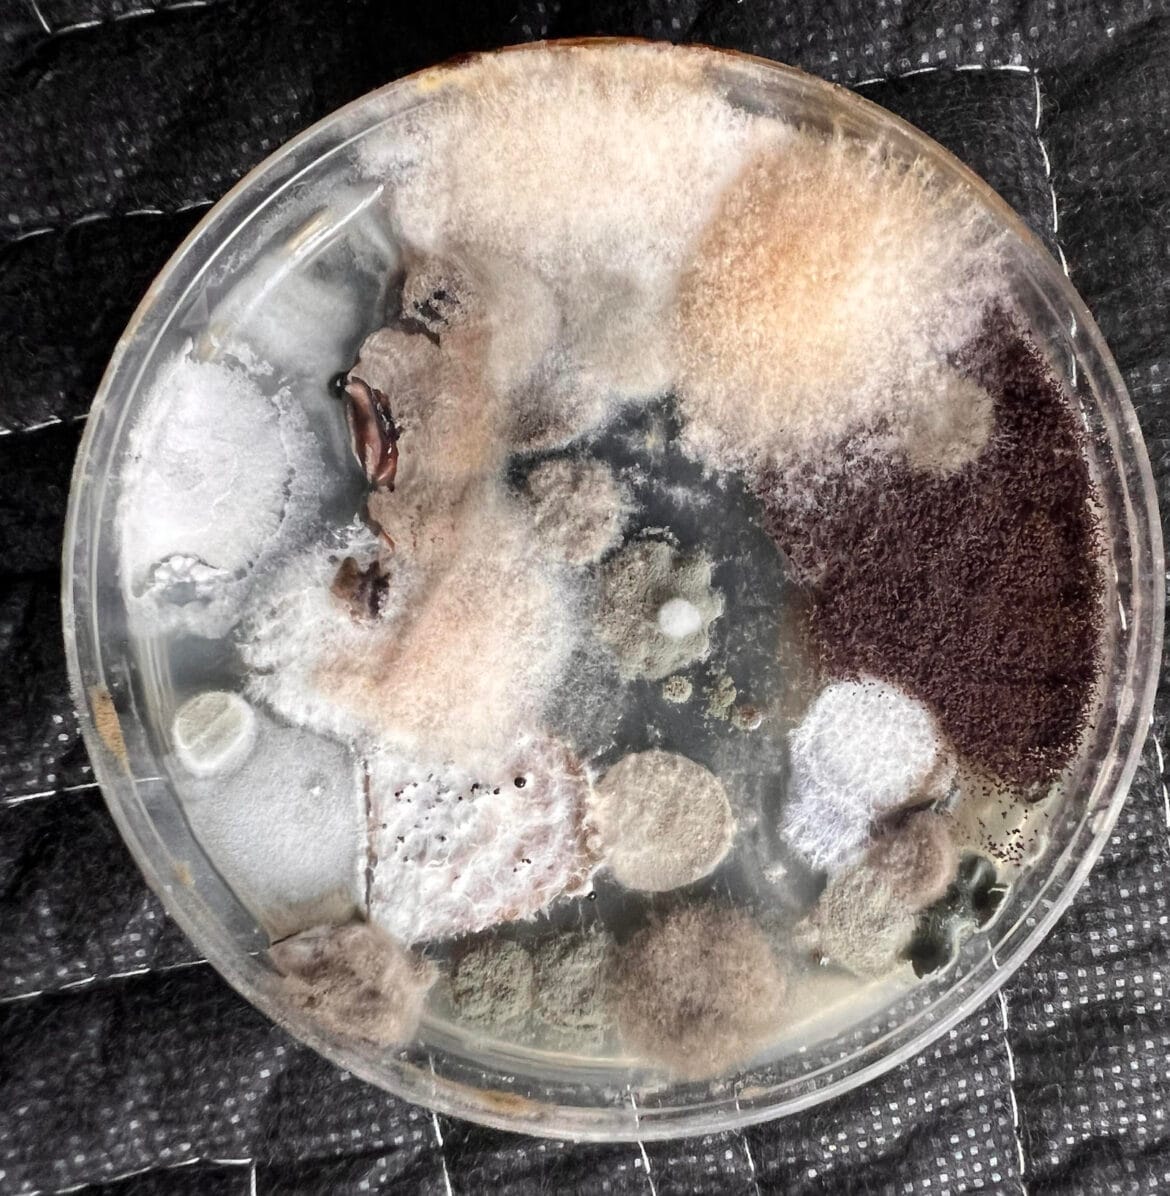

INTRODUCTION
Mold is everywhere in our environment, but being able to identify it is key to ensuring that it doesn’t negatively impact the health and safety of you or your family. Undoubtedly, while living in Florida, or Tampa Bay, you will need to know about mold, mold removal and mold remediation as it’s a very common problem in wet and humid environments.
Let’s go into some facts and details about mold to help you on this journey. Understanding mold is essential to preventing it from growing in your home in the first place.
Some basic facts about mold are:
- Mold is a type of fungus and belongs in the fungus kingdom.
- Mold usually lives and thrives in moist environments. Hence, there tends to be more mold in tropical climates like we have here in Tampa Bay.
- Mold most commonly grows on organic materials, such as biofilms which are found on almost every surface in your home, due to high levels of humidity.
- Mold grows and reproduces by releasing tiny spores into the air. These spores are essentially “seeds” and will grow when they have enough moisture, nutrients and oxygen, unless denatured or destroyed.
- Short-term or prolonged exposure to mold can cause serious health issues, including physical and mental problems due to the release of not only spores, but also mycotoxins (a biotoxin that mold releases as a defense mechanism). [Ref: Oct-Nov 2009 Neurologic and neuropsychiatric syndrome features of mold and mycotoxin exposure]
WHAT IS MOLD?

Mold can have several colors including but not limited to black, green & white. It can be fuzzy in appearance or even “chalky” in some cases”.
Simply put, mold is a fungus that has a vital role in our ecosystem. Mold breaks down dead organic material into basic elements which are used by organisms for other natural processes. Without mold and other fungi, the cycle of our ecosystems would have a hard time continuing.
While it’s essential for the ecosystem, mold can pose serious issues to humans. Symptoms of mold exposure can be relatively mild, like a runny nose and itchy eyes, to severe symptoms such as mold-induced asthma to neurological diseases. Some diseases of animals and humans can be caused by certain molds. The disease may result from allergic sensitivity to mold spores, growth of pathogenic molds within the body, or from the effects of ingested or inhaled toxic compounds (mycotoxins) produced by molds.
WHERE DOES MOLD LIVE AND GROW?

Different mold species can grow in a multitude of environments, however all mold needs moisture to survive and can even live in a well-lit area. Using specialized tools to locate mold is key to handling the source of the problem.
Mold typically grows in warm and moist areas in nature, or more dangerously, in your home or workspaces. Not all mold needs to live in moist areas, however. Some species of mold are known to grow better in areas with less moisture than you might think.
Some molds produce small. Spores are tiny, very light-weight and are adapted for wind dispersal. These spores may remain airborne for long periods of time. This is why an atomized sanitization approach, similar to what Mold Solutions USA uses on every mold removal project, is so important. Although not an “end all, be all” handling (source removal is so crucial) a “dry fog” that replicates the motion and movement of a tiny mold spore is a very effective step in the complete mold handling.
In some molds, the spore cell walls are darkly pigmented, providing resistance to damage by ultraviolet radiation. Other mold spores have slimy sheaths and are more suited to dispersal through water. These water-molds are normally considered “zero tolerance” mold spores because they are indicative of water damage and mold being behind building materials such as kitchen cabinets or drywall. These molds can also produce highly toxic mycotoxins that can easily move into the environment due to air flow as they are even smaller and lighter than mold spores.
To reproduce, mold will release spores into the air that find their way to locations which are suitable for them to germinate and grow. Unfortunately, they sometimes find their way into the air we breathe, causing a variety of symptoms in our bodies. In some cases they can even start growing in our bodies. As stated earlier, mold spores need water, nutrients and oxygen to grow. Check, check, and check again when it comes to mold growing in or on the human body.
You can find mold growing anywhere its spores can feed on organic material, such as human skin cells, hair and other small particles which tend to build up in dust that is common to our homes. Combined with enough moisture or humidity, you wind up with a jelly-like substance known as a biofilm, which is why you can sometimes find mold growing on materials which are not organic like metallic surfaces and glass.
CONCLUSION
Now that we’ve covered a number of basics on mold and how it grows, the next step is prevention. Key to preventing mold is by limiting the amount of moisture that it needs to survive. A good baseline to think with is keeping your home under 60% relative humidity.
Here are a few tips you can use to reduce moisture in your home:
- Keep your A/C running
The Air Conditioning unit in your home helps to keep it cool, but it also has an incidental function of removing moisture in the air. Without moisture, most molds will have trouble growing. Also consider a dehumidifier in your home as well. Never leave your AC in the “ON” position. “Auto” allows the system to turn on and off, giving the coils a chance to dry out. Be careful not to run your AC too low. If you run your AC below 69 degrees (and in some cases even below 74 in summer months) you are likely to create a condensation problem that leads to, you guessed it, more mold. - Maintain proper air flow in your home:
As simple as this sounds, keeping the air in your home or workplace moving can help to remove excess moisture, thereby removing one of the key elements mold needs to grow. This is why fans play such an important role here in Pinellas County. In some cases where there are high ceilings, you should reverse the direction of airflow so that the air blows upwards, preventing mold from landing and germinating due to high levels of humidity in these higher areas with no cooling from the AC. - Use an air purifier, ideally a whole home air purification system.
Air purifiers, especially those placed in the plenum box of your AC unit, combined with MERV 7 to 9 air filter, can remove mold spores from the air you and your family breathes. Stopping mold spores from growing in the first place is an excellent way to prevent mold growth. (But don’t forget to change them every two months or so!) Moldy filters, otherwise known as filters with “bio-nesting” result in poor air quality & have caused more than one or two families to get sick! - UV Lights installed next to the blower wheel on your AC.
We’ve had so many AC units here in Tampa Bay completely contaminated with mold, due to mold growth on the blower wheel from condensation that comes from being too close to the ice cold coils. Mold on the blower wheel equals mold in your AC ducts with mold spores and mycotoxins blowing all over the house. Not a good problem to have but it’s one that Mold Solutions USA solves everyday. A UV light near the blower wheel can make all the difference when it comes to mold growth in the AC unit and ducts.
With that being said, you’re well on your way to spotting and preventing mold growth in your home.
While it’s possible to reduce the amount of mold in your environment, there is no way to have a 100% mold-free home. Mold is here to stay, but keeping it at bay will undoubtedly result in a healthier life for you and your family.
Are you concerned that you have mold growing in your home? Consider an environmental inspection by one of our certified professionals.
Mold Solutions USA